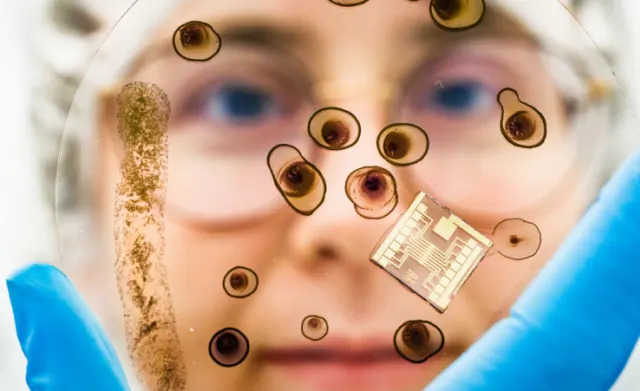

Forschung
Nachhaltigere Erzeugung organischer Chips
Wissenschaftler der Universität Linköping haben eine umweltfreundlichere Methode zur Herstellung leitfähiger Tinten für den Einsatz in organischer Elektronik wie Solarzellen, künstlichen Neuronen und weichen Sensoren entwickelt. Dies könnte den Weg für künftige nachhaltige Technologien ebnen. Details sind in "Nature Communications" nachzulesen.
Mehr organische Elektronik
Organische Elektronik ist auf dem Vormarsch als Ergänzung oder Ersatz für siliziumbasierte Elektronik. Dank simpler Produktion, hoher Flexibilität und geringen Gewichts in Verbindung mit elektrischen Eigenschaften, die mit herkömmlichen Halbleitern verbunden sind, verspricht sie grossen Nutzen für Anwendungen wie digitale Displays, Energiespeicher, Solarzellen, Sensoren und weiche Implantate.
Erzeugt wird organische Elektronik aus halbleitenden Kunststoffen, sprich konjugierten Polymeren. Deren Verarbeitung erfordert jedoch häufig umweltschädliche, giftige und entflammbare Lösungsmittel - ein grosser Hemmschuh für die breite kommerzielle und nachhaltige Nutzung organischer Elektronik. Die von den Linköpinger Forschern entwickelte neue nachhaltige Methode zur Verarbeitung dieser Polymere aus Wasser sorgt für nachhaltigere und hochgradig leitfähige neue Tinte.
Ohne giftige Chemikalien
"Unsere Forschung führt einen neuen Ansatz zur Verarbeitung konjugierter Polymere unter Verwendung unschädlicher Lösungsmittel wie Wasser ein. Mit dieser Methode, dem sogenannten Grundzustandselektronentransfer, umgehen wir nicht nur das Problem der Verwendung gefährlicher Chemikalien, sondern können auch Verbesserungen der Materialeigenschaften und der Geräteleistung nachweisen", so Simone Fabiano, Senior Associate Professor am Laboratory of Organic Electronics.
Als die Forscher die neue leitfähige Tinte als Transportschicht in organischen Solarzellen getestet haben, fanden sie heraus, dass sowohl die Stabilität als auch die Effizienz höher waren als bei herkömmlichen Materialien. Sie testeten die Tinte auch zur Herstellung elektrochemischer Transistoren und künstlicher Neuronen, wobei sie ähnliche Betriebsfrequenzen wie biologische Neuronen nachweisen konnten.
"Ich glaube, dass diese Ergebnisse einen transformativen Einfluss auf den Bereich der organischen Elektronik haben können. Indem wir die Verarbeitung organischer Halbleiter mit umweltfreundlichen und nachhaltigen Lösungsmitteln wie Wasser ermöglichen, können wir elektronische Geräte mit minimalen Auswirkungen auf die Umwelt in Massenproduktion herstellen", erklärt Fabiano abschliessend.











Kommentare